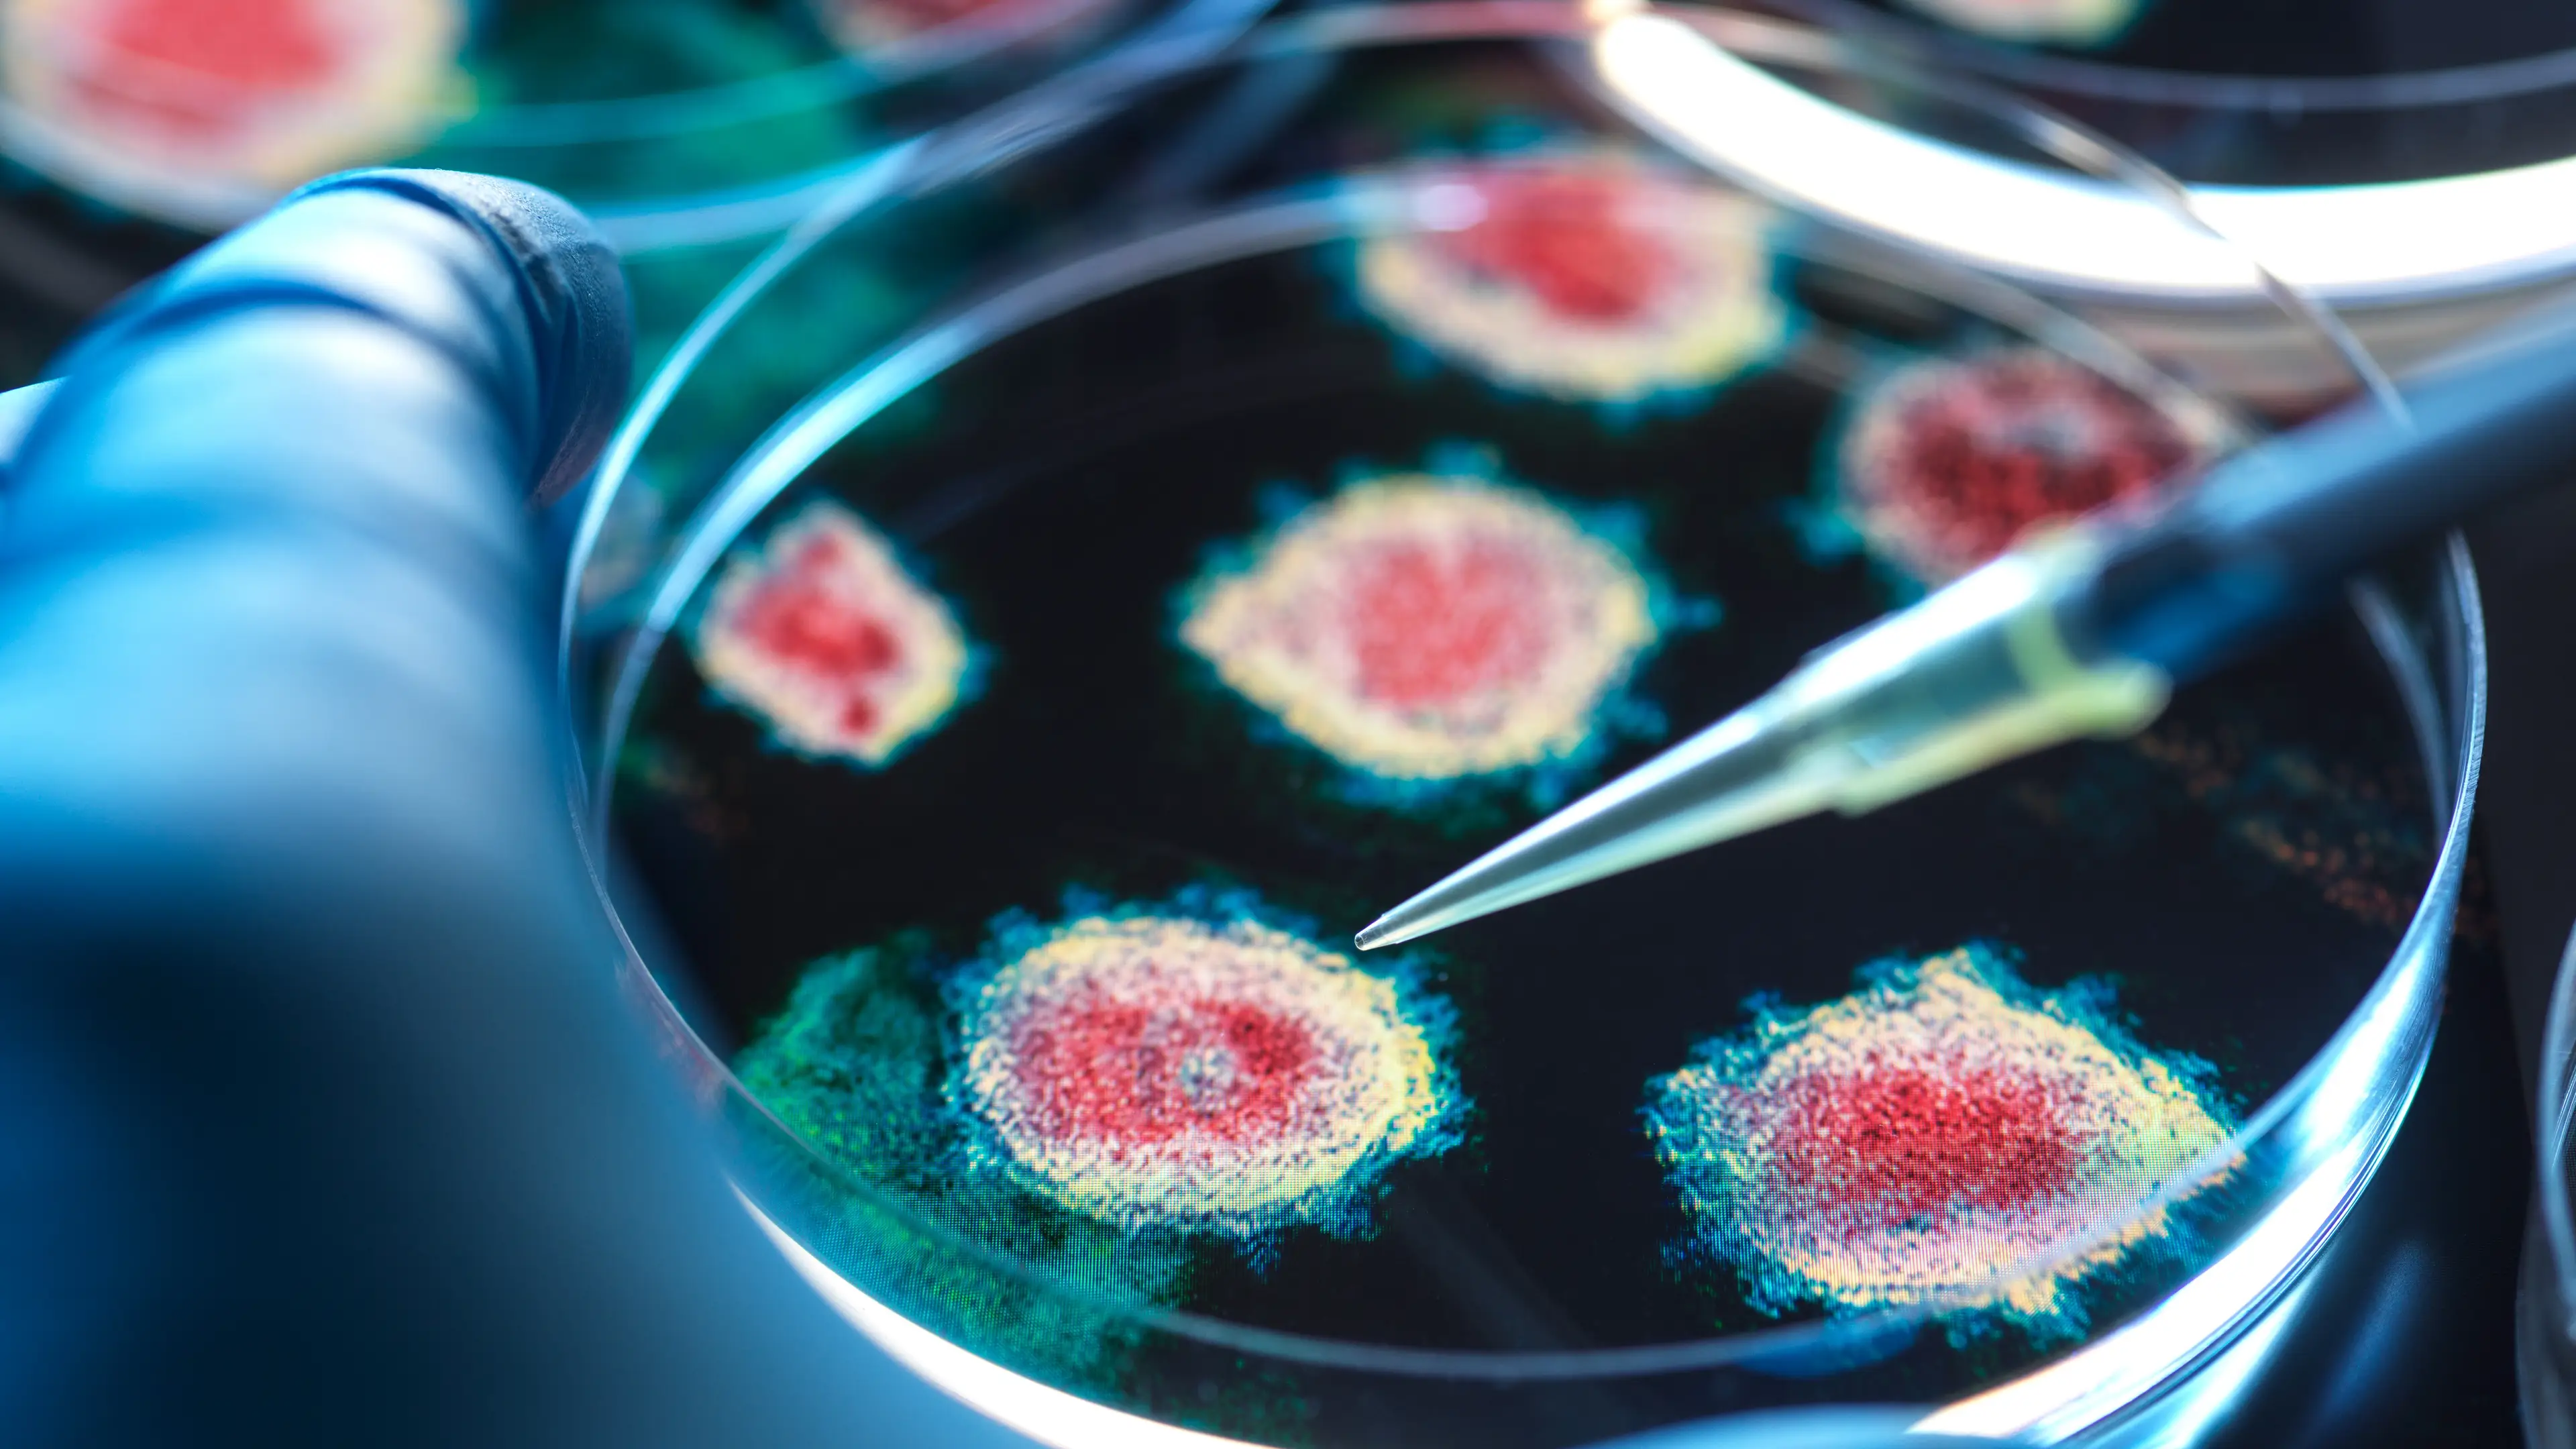
Getty Stock Images

True Life
Real-life stories, news and experiences from around the world that are sure to shock, intrigue and entertain you.
Real-life stories, news and experiences from around the world that are sure to shock, intrigue and entertain you.
Real-life stories, news and experiences from around the world that are sure to shock, intrigue and entertain you.